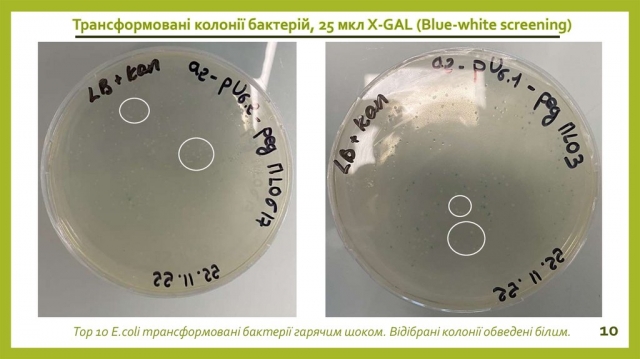

Студенти факультету захисту рослин, біотехнологій та екології захистили бакалаврські кваліфікаційні роботи!
З 5 по 20 травня проходила весняна екзаменаційна сесія, яку студенти факультету захисту рослин, біотехнологій та екології успішно завершили склавши 27 екзаменів. Наші студенти встигають навчатися, працювати, проходити практику та стажування, волонтерити, займатися благодійністю, організовувати різного роду заходи на підтримку одногрупників, котрі знаходиться в лавах ЗСУ, й на підтримку свого морального стану. За останні 1,5 року багато студентів втратили домівку знайшовши прихисток за кордоном, проте продовжили навчання в НУБіП України відвідуючи в режимі онлайн лекції та практичні заняття, вести дослідження на базі лабораторій.


Після попереднього заслуховування фінальних робіт на засіданнях кафедр, після перевірки на достовірність, новизну та унікальність протягом 12-16 червня на факультеті захисту рослин, біотехнологій та екології проходив захист кваліфікаційних робіт на здобуття ОС «Бакалавр». Захист проходив в змішаному форматі для випусників денної та заочної форм навчання за спеціальностями 101 «Екологія», 162 «Біотехнології та біоінженерії», 202 «Захист і карантин рослин». Варто зазначити, що студенти спеціальності 202 «Захист і карантин рослин» перед захистом бакалаврських робіт вже пройшли державний екзамен.

Зі вступним словом до здобувачів та комісії звернулася декан факультету, професор Юлія Коломієць, яка щиро побажала успішного захисту бакалаврських робіт. Заступники декана, доценти Валерія Бондарь, Петро Дрозд та Оксана Сикало зачитали наказ ректора про склад екзаменаційної комісії, ознайомили присутніх із регламентом проведення захисту. Окрім того, зовнішньою оцінкою на чолі з Лідією Галайдюк — начальника відділу з працевлаштування випускників та видачі документів про вищу освіту НУБіП України, яка завітала до студентів факультету захисту рослин, біотехнологій та екології перед початком захисту, було визначено, що нестатутні відносини між викладачами й здобувачами вищої освіти відсутні.



На захисті спеціальності 101 «Екологія» контролювала якість дипломних робіт та рівень підготовки випускників екзаменаційна комісія у складі: голова комісії Алла Клепко — доктор біологічних наук, старший науковий співробітник, завідувач кафедри загальної екології, радіобіології та безпеки життєдіяльності, гарант освітньої програми Володимир Боголюбов — професор, доктор педагогічних наук кафедри загальної екології, радіобіології та безпеки життєдіяльності, член комісії Олена Наумовська — кандидат сільськогосподарських наук, доцент, завідувач кафедри екології агросфери та екологічного контролю, секретар комісії Володимир Іллєнко — старший викладач, кандидат біологічних наук кафедри загальної екології, радіобіології та безпеки життєдіяльності.


До уваги екзаменаційної комісії було представлено 58 робіт студентів денної форми навчання та 11 робіт студентів заочної форми. Слід відзначити студентів, роботи яких особливо сподобалися всім членам комісії. Серед них, Вероніка Угня, яка виконала бакалаврську роботу на тему «Річкові екологічні коридори Сумської області», науковий керівник к.с.-г.н., доцент Людмила Вагалюк. Основним шляхом збереження біологічного різноманіття є створення екологічної мережі. Екологічні коридори забезпечують її стійкість, зазначає Вероніка. Метою дипломної роботи стало дослідження стану річкових екологічних коридорів для збереження біорізноманіття рослин-гідробіонтів екомереж Сумської області, на прикладі річки Десна.

Вероніка підкреслила, що аналіз стану поверхневих вод досліджуваних річок басейну річки Десна, на основі індексу забруднення води показав, що якість вод досліджуваних річок відносить до ІІІ класу (слабозабруднені). Виходячи з побудованої локальної схеми Деснянського річкового екологічного коридору, можна стверджувати що дана сполучна територія є одним з найважливіших міграційних шляхів регіону. Річка Десна, що протікає територією національного природного парку «Деснянсько-Старогутський» та сполучаючи між собою інші об’єкти природно-заповідного фонду, переносячи генетичний метеріал особливо цінних видів, які проживають на їх території. Деснянський річковий екологічний коридор гарантує збереження зв’язності, міграції та розселення видів, а отже збереження їх популяцій і біорізноманіття.

«На основі проведеного аналізу антропогенного впливу на річки басейну Десна, можна стверджувати, що основними джерелами антропогенного навантаження є комунальні установи, які скидають не очищенні або недостатньо очищенні стічні води в поверхневі водні об’єкти, сільське господарство та промисловість. Всі вони тягнуть за собою прямий або опосередкований вплив на рівень міграції», — зазначила Вероніка Угня.

Ванесса Гебре працювала над темою «Вивчення ступеню антропогенного навантаження на ландшафт міста Цукуба, Японія», науковий керівник к.с.-г.н., старша викладачка Ганна Сербенюк. Серед основних завдань Ванесса виділила дослідження екологічного стану міста в аспектах земельних ресурсів, водних об’єктів, атмосферного повітря та утилізації побутових відходів, аналіз антропогенного навантаження на ландшафт найбільш розповсюдженими чинниками в місті, а також визначення екологічних проблем та подальші шляхи покращення екологічного стану міста.

Провівши дослідження за розробленою Петром Шищенко методикою Ванесса Гебре виявила, що ландшафти в місті Цукуба оцінюються, як сильноперетворені, а за співвідношенням природних та змінених природно-територіальних комплексів — як антропогенні. На основі отриманих даних вона окреслила основні причини впливу антропогенного навантаження на ландшафт. В першу чергу, це сільськогосподарські угіддя, адже вони займають найвищу частку в регіоні серед землекористування, що становить майже 60% від загальної площі міста. Тут в основному вирощують рис, лотос, бамбук та інші культури. Другим чинником антропогенного навантаження на ландшафт є забудова міста. Місто Цукуба було засноване з метою «розвантаження» столиці Токіо, та задля створення унікального містечка науки. Проте розвиток міст завжд характеризується швидкою та безперервною урбанізацією в безпрецедентних масштабах, зі швидким економічним зростанням. Результатом стала розгалужена міська забудова та вплив на місцеве навколишнє середовище.

«Проте частка природних територій складає всього навсього 2,4% від загальної площі міста, що є доволі низьким показником. Важливо зробити навколишнє середовище міста Цукуба більш привабливим, проактивно визначаючи внутрішні та міжнародні тенденції, а також зміцнюючи екологічні сильні сторони міста та покращуючи його слабкі сторони», — наголосила Ванесса.

Уляна Ліхацька виконала дипломну роботу на тему «Екофітобіотичний аналіз поширення амброзії полинолистої на території міста Сміла», науковий керівник д.біол.н., професор Віталій Гайченко. Уляна наголосила, що поширення амброзії полинолистої (Ambrosia artemisiifolia L.) є досить серйозною проблемою, оскільки цей карантинний бур’ян являється не тільки одним з найбільш алергенних рослин, який може викликати сильну алергічну реакцію у людей, але й має неабиякий вплив на навколишнє середовище, включаючи всі його елементи.

Основними завданнями роботи Уляна зазначила:
- вивчити залежність темпів зростання рослини від особливостей дослідного екотопу – екологічних факторів (ступеню зволоженості, інсоляції, типу ґрунту тощо).
- проаналізувати методи боротьби, що використовуються та запропонувати найефективніший без впливу на біорізноманіття навколишнього середовища;
- висвітлити проблему на основі актуальних наукових досліджень задля привернення уваги громадськості та представників державних установ до необхідності запустити механізм формування загальнодержавної програми з протидії загрозам, які обумовлені натуралізованим видом.

Уляна Ліхацька підкреслила, що найбільш засміченими ділянками виявились поле для мотокросу та залізнична станція «Імені Тараса Шевченка» з найвищим показником рясності карантинного бур’яну. Встановлено, що екологічні умови в досліджених локалітетах зумовлюють оптимальні умови для активної експансії амброзії, схожі з умовами батьківщини рослини. Порівняння отриманих матеріалів зі схожими за екологічними умовами ділянками у місті. На підставі проведеного дослідження стає очевидним, що головним чинником, що обумовлює розповсюдження амброзії полинолистої в міських агломераціях, є господарська діяльність.

На захисті спеціальності 162 «Біотехнології та біоінженерії» працювала екзаменаційна комісія в наступному складі: голова комісії Світлана Прилуцька — доктор біологічних наук, старший науковий співробітник, завідувач кафедри фізіології, біохімії рослин та біоенергетики, гарант освітньої програми Оксана Кляченко — професор, доктор сільськогосподарських наук кафедри екобіотехнології та біорізноманіття, член комісії Олена Кваско — кандидат біологічних наук, завідувач кафедри екобіотехнології та біорізноманіття, секретар комісії Наталія Нестерова — кандидат сільськогосподарських наук, доцент кафедри фізіології, біохімії рослин та біоенергетики.



До уваги екзаменаційної комісії було представлено 50 робіт студентів денної форми навчання та 11 робіт студентів заочної форми. Слід відзначити студентів, роботи яких особливо сподобалися всім членам комісії, а саме Анастасія Шевченко, яка виконала дипломну роботу на тему «Вплив температури зберігання на гемоглютинуючі властивості вірусів – основи біовакцин», науковий керівник д.с.-г.н., доцент Віра Бородай. Вона підкреслила актуальність обраної теми наголосивши на тому, що хвороба Ньюкасла вважається однією з найважливіших вірусних, з точки зору поширення в світі та економічного впливу, хвороб свійської птиці, що суттєво заважає розвитку птахівництва у світі. Хвороба особливо важлива для курей, у цій галузі вона завдає величезних економічних збитків через високу смертність, зниження виробництва яєць, а також обмеження міжнародною торгівлею птицею та продуктами з неї. Метою її роботи стало дослідження впливу температури зберігання основи біовакцин, як об’єкт досліджень Аліна зазначила оптимізацію біотехнології виробництва вакцин, а саме: визначення найоптимальнішої температури для тривалого зберігання вірусовмісного матеріалу, а також речовину-інактивант та ад’ювант, що дозволяють зберегти гемаглютинуючі властивості вакцинного вірусу на високому рівні.

«Сучасною тенденцією в боротьбі з вірулентною інфекцією є розробка вакцин, відповідних за генотипом, на основі ізолятів вірусу хвороби Ньюкасла, які зараз циркулюють. Доведено, що ці вакцини є більш ефективними не тільки в профілактиці захворювань, але й у блокуванні реплікації та виділення вірулентного вірусу після зараження. Тож, розробка ефективних вакцин є одним з найважливіших завдань сучасної біотехнології», — наголосила Аліна Шевченко.

Дарина Пасевич захищала бакалаврську роботу на тему «Вплив регуляторів росту на здатність до регенерації експлантатів гіпокотилю льону (Linum usitatissimum L.) у культурі in vitro», науковий керівник д.с.-г.н., професор Юлія Коломієць.

Дарина Пасевич зазначила, що рід Linum налічує приблизно 300 видів, більшість з яких дикорослі, деякі вирощуються як декоративні рослини, деякі волокнисті форми набули локального значення, однак зазвичай культивується лише один вид льону, тобто L.usitatissimum. Метою її роботи стала оптимізація умов культивування калюсоутворення та проліферації клітин у рідкому середовищі, визначення впливу різних концентрацій регуляторів росту на здатність до регенерації експлантатів гіпокотилю сортів льону звичайного (Linum usitatissimum L.), а об’єктом дослідження виступив рослинний матеріал двох сортів льону: Гладіатор і Сіверський.


Дарина підвела підсумки дослідження та поділилася результатами після 16 й 28 діб культивування на середовищі, як одного із варіантів, з додаванням 0,5 мг/л БАП і 0,05 мг/л НОК. Серед досліджуваних комбінацій регуляторів росту рослин найвища частота утворення калюсу спостерігалася на середовищі з додаванням БАП та НОК. Висока концентрація цитокініну (БАП) у рідкому живильному середовищі обмежує проліферацію клітин і знижує утворення біомаси. Найвищу ефективність регенерації спостерігалася на середовищах з додаванням 1 мг/л 6-БАП.

Тетяна Гунько виконала дипломну роботу на тему «Редагування послідовностей ДНК у виноградної лози за допомогою CRISPR», науковий керівник д.б.н., професор Світлана Прилуцька. Тетяна наголосила, що тема є актуальною, адже борошниста роса є одним з найрозповсюдженіших патогенів виноградної лози, особливо вразливими є сорти винограду, котрі відносяться до виду Vitis vinifera. Застосування фунгіцидів не є ефективним рішенням при боротьби з патогеном, тому створення стійких сортів здатних поєднувати одночасно якісні ознаки винограду та стійкість до збудника є актуальним та відкритим питанням.

CRISPR (Clustered Regularly Interspaced Short Palindromic Repeats) — система для редагування генному є ідеальним інструментом, котрий може стати в нагоді при розробці генетично стійких сортів рослин, адже схожі дослідження були проведені для інших рослин і отримані результати були цілком задовільними. Метою роботи Тетяни була розробка та застосування PE техніки редагування генному для генів MLO у виноградній лозі. Свою роботу вона виконувала на базі дослідницької лабораторії підрозділу AGAP науково-дослідницького центру CIRAD у Монпельє, Франція, під керівництвом Valérie LAUCOU та Céline GEORGET.
Тетяна Гунько застосувала наступні методи дослідження: біоінформатичні, молекулярні, мікробіологічні, цитологічні. Вона детально розповіла про всі процеси досліджень, складнощі та відкриття на базі дослідницької лабораторії. «Ембріогенний калус сортів Grenache та Portan був трансформований методом агробатеріальної трансформації. Через три тижня після трансформації чашки з калусом Portan були контаміновані бактерією та були виключені з подальшого дослідження. Калус Grenache продемонстрував диференціацію тканин у вигляді піків за цей термін», — підкреслила один із висновків роботи Тетяна.

На захисті спеціальності 202 «Захист і карантин рослин» до складу комісії увійшли: голова комісії Лариса Пасічник — кандидат сільськогосподарських наук, доцент кафедри ентомології, інтегрованого захисту та карантину рослин, гарант освітньої програми Мирослав Піковський — доктор сільськогосподарських наук, доцент кафедри фітопатології ім. акад. В.Ф. Пересипкіна кафедри фітопатології імені акад. В.Ф. Пересипкіна, член комісії Ярослав Лікар — кандидат сільськогосподарських наук, доцент кафедри ентомології, інтегрованого захисту та карантину рослин, секретар комісії Леся Бондарева — доцент кафедри ентомології, інтегрованого захисту та карантину рослин.


До уваги екзаменаційної комісії було представлено 58 робіт студентів денної форми навчання та 6 робіт студентів заочної форми. Слід відзначити студентів, роботи яких особливо сподобалися всім членам комісії. Наприклад, Руслан Круковський працював над бакалаврською кваліфікаційною роботою на тему «Особливості розвитку фузаріозного в’янення огірка та екологічні особливості гриба Fusarium oxysporum Schltdl», науковий керівник доктор с.-г. наук, доцент Мирослав Піковський.

Руслан підкреслив, що на рослинах огірка поширена велика кількість хвороб – борошниста роса, антракноз, аскохітоз, біла гниль, сіра гниль тощо. Однією з найпоширеніших хвороб огірків є саме фузаріозне в’янення, збудником якої є гриб Fusarium oxysporum f. sp. cucumerinum Оwen. Разом з тим, втрати врожаю, в окремі роки, можуть становити до 60 %. Метою роботи Руслана Круковського стало вивчення симптоматики фузаріозу огірка, екологічних особливостей гриба Fusarium oxysporum f. sр. cucumerinum Owen, де основним завданням було встановити діагностичні ознаки фузаріозу, дослідити динаміку розвитку хвороби, ізолювати гриб Fusarium oxysporum та вивчити екологічні властивості його штамів.

Вегетаційні дослідження проводились в умовах НЛ «Плодоовочевий сад» НУБіП України. Лабораторні дослідження проводили в умовах проблемної науководослідної лабораторії «Мікології і фітопатології» кафедри фітопатології ім. акад. В.Ф. Пересипкіна. За результатами проведених досліджень Руслан встановив, що оптимальною температурою для розвитку гриба є + 25 °С. Встановлено штамові відмінності гриба Fusarium oxysporum щодо температурного фактора, зокрема штам № 1 характеризувався найшвидшим радіальним ростом колонії (84 мм на 9 добу культивування). Серед досліджуваних поживних середовищ, найбільш оптимальним для росту та спороутворення гриба був картопляно-глюкозний агар. Загалом, дослідження впливу різних факторів на збудника фузаріозного в’янення огірка дозволить зрозуміти екологію патогену.

Назар Тарнавський досліджував тему «Моніторинг, біоекологічні особливості розвитку і шкідливість каштанової мінуючої молі (Cameraria ohridella)», науковий керівник кандидат с.-г. наук, доцент Леся Бондарева. Гіркокаштан звичайний, або каштан кінський (Aesculus hyppocastanum L.) завдяки високій декоративності і відносному довголіттю активно використовується у ландшафтній архітектурі не тільки в Києві, а й в інших великих містах, містечках та селах по всій країні. Каштан швидко пристосовується на новому місці після посадки та має середню стійкість до природних та антропогенних впливів характерних для урбанізованої місцевості. Його насадження зменшують забруднення повітря, створюють природний бар’єр від шуму та дарують перехожим прохолодну тінь.

«До недавніх пір гіркокаштан вважався надзвичайно стійким проти патогенів, однак, починаючи з 2003 р., спочатку епізодично, а віднедавна масово, спостерігається пошкодження гіркокаштана хворобами та шкідниками. Гіркокаштан звичайний у нашій країні заселяє 22 види фітофагів, серед яких провідна роль належить саме каштановій мінуючій молі (Cameraria ohridella). Саме тому, дослідження спрямовані на вивчення біології, фенології та екології цього інвайдера є надзвичайно важливими та актуальними для своєчасного та ефективного захисту дерев каштана. Вони є ключовими в розумінні того, як природні та антропогенні фактори навколишнього середовища впливають на популяцію фітофага: динаміку його чисельності та ступінь пошкодження дерев, що в свою чергу дозволяє зрозуміти слабкі та сильні сторони шкідника і розробити дієву систему захисту насаджень каштана», — зазначає Назар Тарнавський.

Дослідження фітосанітарного стану вуличних та паркових насаджень кінського каштана, а також динаміки чисельності каштанової мінуючої молі (Cameraria ohridella) були проведені Назаром влітку 2022 року на території селища міського типу Макарів, що знаходиться у Бучанському районі Київської області. В ході проведення досліджень, Назар Тарнавський представив членам комісії встановлені закономірності: дерева, які знаходилися на ізольованій території Макарівського ліцею №1, протягом місяця зазнали менших пошкоджень від фітофага і мали значно вищу життєздатність та декоративність, у порівнянні з гіркокаштанами, що росли вздовж дороги на вулиці Дмитрія Ростовського. Разом з тим, в ході проведення феромоніторингу за допомогою феромонних пасток, спостерігалась чітка обернена залежність між кількістю впійманих комах та метеорологічними умовами: в період сильних дощів, коли вологість повітря була високою, літ каштанової мінуючої молі практично повністю припинявся, а кількість комах в пастках була близькою до нуля. І навпаки – під час зниження вологості повітря, в сонячну погоду, літ метеликів відновлювався, а динаміка їх чисельності зростала.


Михайло Шаповал досліджував тему «Моніторинг, біоекологічні особливості розвитку і шкідливість ріпакового квіткоїда у посівах ріпаку», науковий керівник кандидат с.-г. наук, доцент Леся Бондарева. Метою його дипломної роботи було проведення моніторингу ріпакового квіткоїда на посівах ріпаку озимого та ярого, який включає в себе систему спостережень, контроль поширення, інтенсивність розвитку та обсяг завданої шкоди, а також є головною передумовою для розробки ефективної системи інтегрованого захисту посівів, яка може поєднувати комплекс біологічних, хімічних та агротехнічних заходів. Разом з тим, дослідження біоекологічних особливостей розвитку ріпакового квіткоїда в регіоні досліджень, визначення впливу абіотичних чинників на динаміку чисельності фітофага.

Завдання бакалаврської роботи Михайла:
- Уточнити біологію і екологію шкідника в умовах господарства.
- Визначити чисельність ріпакового квіткоїда на посівах у різні періоди вегетації культури.
- Проаналізувати вплив абіотичних факторів на динаміку заселеності посівів шкідником.

Михайло Шаповал в результаті досліджень дійшов до висновку, що шкідливість ріпакового квіткоїда залежить від погодних факторів, так у холодну погоду та при пізньому цвіті ріпаку імаго здатні знищити значну кількість нерозкритих бутонів. У більш сонячні дні та за раннього настання фази цвітіння жук починає живитися виключно пилком, тому не вигризає та не поїдає генеративні органи рослини. Саме тому, небезпека втрати урожаю на озимому ріпаку більша, але водночас, без належного догляду на ярому може пошкоджуватися 40-60% бутонів. Посіви ріпаку озимого потрібно обробляти хімічними препаратами в залежності від ряду факторів, які включать в себе біологію та дані обліку шкідників, на якому базується прогноз розвитку фітофагів на посівах. В умовах господарства було проведено 2 обробки на озимому ріпаку до початку цвітіння у наступні періоди: Т3 – розвиток бічних пагонів – ріст головного пагону (ВВСН 20-29 та 30-39) – спрямована на контроль прихованохобтників; Т4 – ріст бокових пагонів – бутонізація (ВВСН 40-49 та 50-59) – контроль імаго квіткоїда, насіннєвого прихованохоботника.

До слова, всі виконавці кваліфікаційних робіт продемонстрували високий рівень підготовки, володіння знаннями, разом з тим кожна із представлених робіт базувалася на результатах власних експериментальних досліджень студентів. Екзаменаційна косіміція виділила 29 дипломів з відзнакою (7 студентів екологів, 12 студентів біотехнологів, 10 спеціалістів із захисту та карантину рослин). Два іноземця спеціальності 101 «Екологія», а саме Джаллоу Шеріф Аласан та Буендіа Понтон Джонатан Паул зовсім скоро зможуть примінити набуті знання в Україні для своїх держав — Гани та Іспанії. Окрім того, захистили дипломні роботи й студенти, котрі служать в лавах ЗСУ, а саме Олексій Капралов, Іван Тімофєєв, Борис Дацишин, Христина Костенко, Дмитрій Шапа, Світлана Торовчик.





Щиро вітаємо студентів та їх наукових керівників із успішним захистом бакалаврських робіт! Вдячні головам та членам комісії за продуктивну роботу, конструктивну критику, за витримку та професіоналізм. Дякуємо нашим студентам за плідне навчання та наполегливість. Запрошуємо всіх випускників продовжити навчання на магістратурі факультету захисту рослин, біотехнологій та екології!
Наталія Батрак